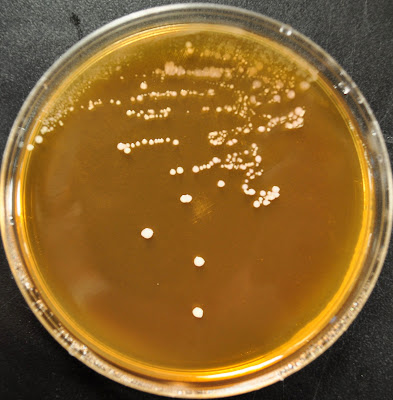

Pediococcus plated on The Bruery's lab media
Meet some of the microorganisms that are responsible for the beer made at The Bruery.
Yes, it’s true, you are sharing your beer with other living things. Since all of our beers here at The Bruery are unfiltered, they are indeed alive when you sit down to enjoy your drink. The delicate and bold flavors produced through fermentation help give beer the unique properties you experience along with the quality of the ingredients used. While there are a variety of cultures used at The Bruery, some are more important than others. They are Brettanomyces, Lactobacillus, and Pediococcus. Their importance is because of their roles as both fermentative species and contaminants.
Brettanomyces is considered a wild yeast and is noted for the “farmhouse” flavor profile that it produces in beer. Lactobacillus and Pediococcus are lactic acid producing bacteria. They are used in the fermentations of food products such as sauerkraut, yogurt, cheese, chocolate, and kimchi. Lactic acid bacteria are used in the production of lambic-style ales, Flemish-style red ales and other similar beers; they produce the lactic acid that gives these beers their characteristically sour taste.
While these organisms can be used to make wonderful and complex beers, they can also prove to be persistent contaminants. The flavors created through their fermentative action can frequently produce unfavorable sensory characteristics in beer in which their presence is not intended. Simply put, we want to control microbial fermentation in our beer so that the flavors we target are found only in the final product of specific beers, not all of our beers.
To this end, the quality control process is our greatest tool. Since brewing uses living organisms, we are at the mercy of these yeast and bacteria. Exhibiting control over the process gives brewers the power to create the final product that they have in mind. There have even been historical European brewers quoted as saying that god is truly the maker of beer, we simply help guide it along it's path.
Long before the bottle reaches your lips, steps are taken to make sure the quality is maintained. We utilize a number of preventative measures to ensure that a 'bad beer' is never something that you, the consumer, have to experience in connection with our brand.
These measures include regular and thorough tank cleaning, and lab testing at many intervals in the brewing and aging process. In short, all our beer is sampled and tested at various stages during their fermentation and development - including bottling and kegging. All samples are plated on selective and differential media that allow us to see what, exactly, is in our beers. Rest assured that when you are enjoying a hand-crafted Bruery beer, much effort has been invested into ensuring that you receive the finest fermented beverage on the market.
--Kristen Bennett
Laboratory Intern and Technician
While these organisms can be used to make wonderful and complex beers, they can also prove to be persistent contaminants. The flavors created through their fermentative action can frequently produce unfavorable sensory characteristics in beer in which their presence is not intended. Simply put, we want to control microbial fermentation in our beer so that the flavors we target are found only in the final product of specific beers, not all of our beers.
To this end, the quality control process is our greatest tool. Since brewing uses living organisms, we are at the mercy of these yeast and bacteria. Exhibiting control over the process gives brewers the power to create the final product that they have in mind. There have even been historical European brewers quoted as saying that god is truly the maker of beer, we simply help guide it along it's path.
Long before the bottle reaches your lips, steps are taken to make sure the quality is maintained. We utilize a number of preventative measures to ensure that a 'bad beer' is never something that you, the consumer, have to experience in connection with our brand.
These measures include regular and thorough tank cleaning, and lab testing at many intervals in the brewing and aging process. In short, all our beer is sampled and tested at various stages during their fermentation and development - including bottling and kegging. All samples are plated on selective and differential media that allow us to see what, exactly, is in our beers. Rest assured that when you are enjoying a hand-crafted Bruery beer, much effort has been invested into ensuring that you receive the finest fermented beverage on the market.
--Kristen Bennett
Laboratory Intern and Technician
Brettanomyces plated on The Bruery's lab media
Close up of Lactobaccilus bacteria. Hello little friends!
Lactobaccilus bacteria plated on The Bruery's lab media

No comments:
Post a Comment